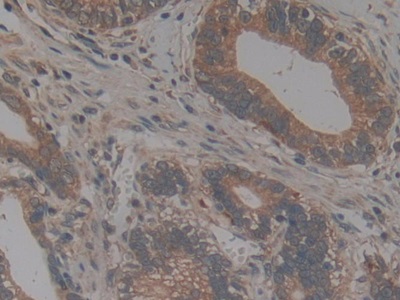
https://d1vffmuvmgkypt.cloudfront.net/image/ridacom_ltd/cloud_clone_corp/PRODUCT_SOURCE__CLOUD_CLONE__SUPPLIER__RIDACOM__ID__PAA040Hu02__4

Antigen
NTN
Reactivity
Human
(10)
Rat
(7)
Mouse
(4)
Research area
Autoimmunity
(14)
Cytokine
(14)
Infection immunity
(14)
Rheumatology
(14)
Signal transduction
(1)
Application
Western Blotting
(12)
Immunocytochemistry
(8)
Immunohistochemistry
(8)
Enzyme-linked immunosorbent assay for Antigen Detection
(4)
Immunoprecipitation
(4)
Positive Control
(4)
SDS-PAGE
(4)
Chemiluminescent immunoassay for antigen detection
(3)
Cell Culture
(2)
Immunofluorescence
(2)
Host
Rabbit
(4)
293F
(2)
CHO
(2)
Category
Antibodies
(8)
ELISA Kits
(7)
Cell biology
(6)
Immunochemicals
(6)
Protein Biochemistry
(6)
| 48T | $638.00 | |
| 96T | $912.00 | |
| 96T*5 | $4,104.00 |
| 96T*10 | $7,752.00 | |
| 96T*100 | $63,840.00 |
| 48T | $605.00 | |
| 96T | $864.00 | |
| 96T*5 | $3,888.00 |
| 96T*10 | $7,344.00 | |
| 96T*100 | $60,480.00 |
| 48T | $588.00 | |
| 96T | $840.00 | |
| 96T*5 | $3,780.00 |
| 96T*10 | $7,140.00 | |
| 96T*100 | $58,800.00 |

Antigen:
Chemokine C-X3-C-Motif Ligand 1
Synonyms: NTN; ABCD3; C3Xkine; CXC3; CXC3C; NTT; SCYD1; ABCD3; FKN; Neurotactin; Fractalkine; Small Inducible Cytokine Subfamily D(Cys-X3-Cys)Member 1
Reactivity:Rat
Application:Cell Culture
Research area:Cytokine; Infection immunity; Rheumatology; Autoimmunity
| 10µg | $302.00 | |
| 50µg | $756.00 | |
| 200µg | $1,512.00 |
| 1mg | $4,536.00 | |
| 5mg | $11,340.00 |
| 48T | $490.00 | |
| 96T | $700.00 | |
| 96T*5 | $3,150.00 |
| 96T*10 | $5,950.00 | |
| 96T*100 | $49,000.00 |
| 48T | $479.00 | |
| 96T | $684.00 | |
| 96T*5 | $3,078.00 |
| 96T*10 | $5,814.00 | |
| 96T*100 | $47,880.00 |

Antigen:
Chemokine C-X3-C-Motif Ligand 1
Synonyms: NTN; ABCD3; C3Xkine; CXC3; CXC3C; NTT; SCYD1; ABCD3; FKN; Neurotactin; Fractalkine; Small Inducible Cytokine Subfamily D(Cys-X3-Cys)Member 1
Reactivity:Human
Application:Cell Culture
Research area:Cytokine; Infection immunity; Rheumatology; Autoimmunity
| 10µg | $274.00 | |
| 50µg | $684.00 | |
| 200µg | $1,368.00 |
| 1mg | $4,104.00 | |
| 5mg | $10,260.00 |
| 48T | $441.00 | |
| 96T | $630.00 | |
| 96T*5 | $2,835.00 |
| 96T*10 | $5,355.00 | |
| 96T*100 | $44,100.00 |
| 48T | $319.00 | |
| 96T | $455.00 | |
| 96T*5 | $2,048.00 |
| 96T*10 | $3,868.00 | |
| 96T*100 | $31,850.00 |

Antigen:
Chemokine C-X3-C-Motif Ligand 1
Synonyms: NTN; ABCD3; C3Xkine; CXC3; CXC3C; NTT; SCYD1; ABCD3; FKN; Neurotactin; Fractalkine; Small Inducible Cytokine Subfamily D(Cys-X3-Cys)Member 1
Reactivity:Mouse
Application:Positive Control; SDS-PAGE; Western Blotting
Research area:Cytokine; Infection immunity; Rheumatology; Autoimmunity
Preparation method:Escherichia coli
| 10µg | $170.00 | |
| 50µg | $426.00 | |
| 200µg | $852.00 |
| 1mg | $2,556.00 | |
| 5mg | $6,390.00 |

Antigen:
Chemokine C-X3-C-Motif Ligand 1
Synonyms: NTN; ABCD3; C3Xkine; CXC3; CXC3C; NTT; SCYD1; ABCD3; FKN; Neurotactin; Fractalkine; Small Inducible Cytokine Subfamily D(Cys-X3-Cys)Member 1
Reactivity:Rat
Application:Positive Control; SDS-PAGE; Western Blotting
Research area:Cytokine; Infection immunity; Rheumatology; Autoimmunity
Preparation method:Escherichia coli
| 10µg | $168.00 | |
| 50µg | $420.00 | |
| 200µg | $840.00 |
| 1mg | $2,520.00 | |
| 5mg | $6,300.00 |

Antigen:
Chemokine C-X3-C-Motif Ligand 1
Synonyms: NTN; ABCD3; C3Xkine; CXC3; CXC3C; NTT; SCYD1; ABCD3; FKN; Neurotactin; Fractalkine; Small Inducible Cytokine Subfamily D(Cys-X3-Cys)Member 1
Reactivity:Human
Application:Positive Control; SDS-PAGE; Western Blotting
Research area:Cytokine; Infection immunity; Rheumatology; Autoimmunity
Preparation method:Escherichia coli
| 10µg | $152.00 | |
| 50µg | $380.00 | |
| 200µg | $760.00 |
| 1mg | $2,280.00 | |
| 5mg | $5,700.00 |

Antigen:
Chemokine C-X3-C-Motif Ligand 1
Synonyms: NTN; ABCD3; C3Xkine; CXC3; CXC3C; NTT; SCYD1; ABCD3; FKN; Neurotactin; Fractalkine; Small Inducible Cytokine Subfamily D(Cys-X3-Cys)Member 1
Reactivity:Human
Application:Positive Control; SDS-PAGE; Western Blotting
Research area:Cytokine; Infection immunity; Rheumatology; Autoimmunity
Preparation method:Escherichia coli
| 10µg | $152.00 | |
| 50µg | $380.00 | |
| 200µg | $760.00 |
| 1mg | $2,280.00 | |
| 5mg | $5,700.00 |

Antigen:
Chemokine C-X3-C-Motif Ligand 1
Synonyms: NTN; ABCD3; C3Xkine; CXC3; CXC3C; NTT; SCYD1; ABCD3; FKN; Neurotactin; Fractalkine; Small Inducible Cytokine Subfamily D(Cys-X3-Cys)Member 1
Host:293F
Reactivity:Rat
Application:Western Blotting; Immunohistochemistry; Immunocytochemistry; Immunofluorescence
Research area:Cytokine; Infection immunity; Rheumatology; Autoimmunity
| 20µl | $123.00 | |
| 100µl | $287.00 | |
| 200µl | $410.00 |
| 1ml | $1,025.00 | |
| 10ml | $4,100.00 |

Antigen:
Chemokine C-X3-C-Motif Ligand 1
Synonyms: NTN; ABCD3; C3Xkine; CXC3; CXC3C; NTT; SCYD1; ABCD3; FKN; Neurotactin; Fractalkine; Small Inducible Cytokine Subfamily D(Cys-X3-Cys)Member 1
Host:293F
Reactivity:Human
Application:Western Blotting; Immunohistochemistry; Immunocytochemistry; Immunofluorescence
Research area:Cytokine; Infection immunity; Rheumatology; Autoimmunity
| 20µl | $113.00 | |
| 100µl | $265.00 | |
| 200µl | $378.00 |
| 1ml | $945.00 | |
| 10ml | $3,780.00 |

Antigen:
Chemokine C-X3-C-Motif Ligand 1
Synonyms: NTN; ABCD3; C3Xkine; CXC3; CXC3C; NTT; SCYD1; ABCD3; FKN; Neurotactin; Fractalkine; Small Inducible Cytokine Subfamily D(Cys-X3-Cys)Member 1
Host:CHO
Reactivity:Rat
Application:Western Blotting; Immunohistochemistry; Immunocytochemistry
Research area:Cytokine; Infection immunity; Rheumatology; Autoimmunity
| 20µl | $113.00 | |
| 100µl | $263.00 | |
| 200µl | $376.00 |
| 1ml | $940.00 | |
| 10ml | $3,760.00 |

Antigen:
Chemokine C-X3-C-Motif Ligand 1
Synonyms: NTN; ABCD3; C3Xkine; CXC3; CXC3C; NTT; SCYD1; ABCD3; FKN; Neurotactin; Fractalkine; Small Inducible Cytokine Subfamily D(Cys-X3-Cys)Member 1
Host:CHO
Reactivity:Human
Application:Western Blotting; Immunohistochemistry; Immunocytochemistry
Research area:Cytokine; Infection immunity; Rheumatology; Autoimmunity
| 20µl | $104.00 | |
| 100µl | $242.00 | |
| 200µl | $346.00 |
| 1ml | $865.00 | |
| 10ml | $3,460.00 |

Antigen:
Chemokine C-X3-C-Motif Ligand 1
Synonyms: NTN; ABCD3; C3Xkine; CXC3; CXC3C; NTT; SCYD1; ABCD3; FKN; Neurotactin; Fractalkine; Small Inducible Cytokine Subfamily D(Cys-X3-Cys)Member 1
Host:Rabbit
Reactivity:Rat
Application:Western Blotting; Immunohistochemistry; Immunocytochemistry; Immunoprecipitation
Clonality:Polyclonal
Research area:Cytokine; Infection immunity; Rheumatology; Autoimmunity
| 20µl | $103.00 | |
| 100µl | $239.00 | |
| 200µl | $342.00 |
| 1ml | $855.00 | |
| 10ml | $3,420.00 |

Antigen:
Chemokine C-X3-C-Motif Ligand 1
Synonyms: NTN; ABCD3; C3Xkine; CXC3; CXC3C; NTT; SCYD1; ABCD3; FKN; Neurotactin; Fractalkine; Small Inducible Cytokine Subfamily D(Cys-X3-Cys)Member 1
Host:Rabbit
Reactivity:Human
Application:Western Blotting; Immunohistochemistry; Immunocytochemistry; Immunoprecipitation
Clonality:Polyclonal
Research area:Cytokine; Infection immunity; Rheumatology; Autoimmunity
| 20µl | $95.00 | |
| 100µl | $221.00 | |
| 200µl | $316.00 |
| 1ml | $790.00 | |
| 10ml | $3,160.00 |

Antigen:
Chemokine C-X3-C-Motif Ligand 1
Synonyms: NTN; ABCD3; C3Xkine; CXC3; CXC3C; NTT; SCYD1; ABCD3; FKN; Neurotactin; Fractalkine; Small Inducible Cytokine Subfamily D(Cys-X3-Cys)Member 1
Host:Rabbit
Reactivity:Human
Application:Western Blotting; Immunohistochemistry; Immunocytochemistry; Immunoprecipitation
Clonality:Polyclonal
Research area:Cytokine; Infection immunity; Rheumatology; Autoimmunity
| 20µl | $95.00 | |
| 100µl | $221.00 | |
| 200µl | $316.00 |
| 1ml | $790.00 | |
| 10ml | $3,160.00 |

Antigen:
Chemokine C-X3-C-Motif Ligand 1
Synonyms: NTN; ABCD3; C3Xkine; CXC3; CXC3C; NTT; SCYD1; ABCD3; FKN; Neurotactin; Fractalkine; Small Inducible Cytokine Subfamily D(Cys-X3-Cys)Member 1
Host:Rabbit
Reactivity:Mouse
Application:Western Blotting; Immunohistochemistry; Immunocytochemistry; Immunoprecipitation
Clonality:Polyclonal
Research area:Cytokine; Infection immunity; Rheumatology; Autoimmunity
| 20µl | $68.00 | |
| 100µl | $160.00 | |
| 200µl | $228.00 |
| 1ml | $570.00 | |
| 10ml | $2,280.00 |













-APA040Ra01-000001.png)



-SEC169Hu-000001.png)



-SEA040Ra-000001.png)



-APA040Hu02-000001.png)



-SEA040Hu-000001.png)



-SEA040Mu-000001.png)

-PAA040Hu02-000001.png)











